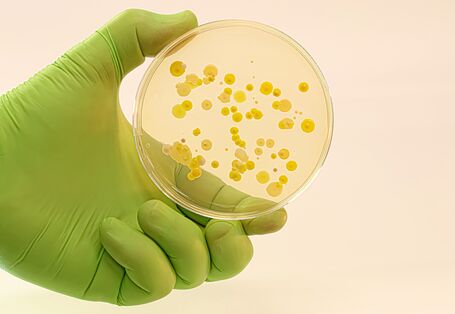
Nahaufnahme von Bakterienkolonien auf einem Nährboden in einer Petrischale

Publication vom 28.06.2022
Spenden Sie Schatten!

… Klima | Energie, Nachhaltigkeit | Strategien | Internationales Spenden Sie Schatten! Werden Sie Teil der Kampagne „Schattenspender“ Die Mitmach-Kampagne … Thema Hitzebelastung auf attraktive und öffentlichkeitswirksame Weise sichtbar zu machen. Zentrales Element ist der Kampagnenleitfaden „Spenden Sie Schatten“, der …